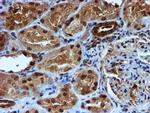
RUVBL2 Antibody in Immunohistochemistry (Paraffin) (IHC (P))

Search
OriGene
RUVBL2 Monoclonal Antibody (OTI1H10), TrueMAB™
{{$productOrderCtrl.translations['antibody.pdp.commerceCard.promotion.promotions']}}
{{$productOrderCtrl.translations['antibody.pdp.commerceCard.promotion.viewpromo']}}
{{$productOrderCtrl.translations['antibody.pdp.commerceCard.promotion.promocode']}}: {{promo.promoCode}} {{promo.promoTitle}} {{promo.promoDescription}}. {{$productOrderCtrl.translations['antibody.pdp.commerceCard.promotion.learnmore']}}
产品信息
TA504284
种属反应
宿主/亚型
分类
类型
克隆号
抗原
偶联物
形式
浓度
规格
纯化类型
保存液
内含物
保存条件
运输条件
靶标信息
Possesses single-stranded DNA-stimulated ATPase and ATP-dependent DNA helicase (5' to 3') activity. Component of the NuA4 histone acetyltransferase complex which is involved in transcriptional activation of select genes principally by acetylation of nucleosomal histones H4 and H2A. This modification may both alter nucleosome - DNA interactions and promote interaction of the modified histones with other proteins which positively regulate transcription. This complex may be required for the activation of transcriptional programs associated with oncogene and proto-oncogene mediated growth induction, tumor suppressor mediated growth arrest and replicative senescence, apoptosis, and DNA repair. The NuA4 complex ATPase and helicase activities seem to be, at least in part, contributed by the association of RUVBL1 and RUVBL2 with EP400. NuA4 may also play a direct role in DNA repair when recruited to sites of DNA damage. RUVBL2 plays an essential role in oncogenic transformation by MYC and also modulates transcriptional activation by the LEF1/TCF1-CTNNB1 complex. May also inhibit the transcriptional activity of ATF2.
仅用于科研。不用于诊断过程。未经明确授权不得转售。
篇参考文献 (0)
生物信息学
蛋白别名: 48 kDa TATA box-binding protein-interacting protein; 48 kDa TBP-interacting protein; 51 kDa erythrocyte cytosolic protein; ECP-51; erythrocyte cytosolic protein, 51-KD; INO80 complex subunit J; Repressing pontin 52; Reptin 52; reptin52 protein; RuvB (E coli homolog)-like 2; RuvB-like 2; RUVBL2; RUVBL2 protein; TAP54-beta; TIP49b; TIP60-associated protein 54-beta; unnamed protein product
基因别名: CGI-46; ECP-51; ECP51; INO80J; REPTIN; RUVBL2; RVB2; TAP54-beta; TIH2; TIP48; TIP49B
UniProt ID: (Human) Q9Y230
Entrez Gene ID: (Human) 10856